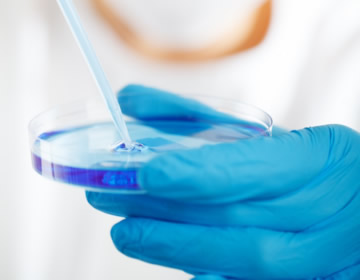

Solución Integral en
Tratamiento de AGUAS

DISEÑO Y CONSTRUCCIÓN
Rediseño, Puesta a punto para cumplimiento con los requerimientos establecidos. (Acuerdo 043 de la CAR, resolución 0631 de 2015).

MANTENIMIENTO
En el tratamiento de aguas residuales, el sistema utilizado debe recibir un mantenimiento adecuado. En SITAGA S.A.S., contamos con personal capacitado para brindar a nuestros clientes mantenimiento preventivo, correctivo y periódico optimizando los sistemas de las plantas (PTAR).

OPERACIÓN
Cubrimos los aspectos y tecnologías del tratamiento del agua y procedimientos de inspección, Vigilancia y control. SITAGA SAS implementa, controla, inspecciona, vigila los procedimientos y actividad referentes a la operación para el cumplimiento de la normatividad vigente.

VENTA DE PRODUCTOS
Suministramos los productos necesarios para los tratamientos químicos del agua.
Experiencia y Profesionalismo en
Gestión AMBIENTAL

ACOMPAÑAMIENTO
MUESTREO Y CARACTERIZACIÓN

ASESORÍAS TÉCNICAS
Basados en diagnóstico previo y análisis fisicoquímicos, microbiológicos y de procesos con el fin de determinar los sistemas como procesos adecuados para cada planta en el cumplimiento de las normas y optimización de los recursos.

ANÁLISIS DEL AGUA
Realizar análisis Físico – Químicos del agua, evaluando los resultados frente a los estándares de calidad para agua potable y residual.


